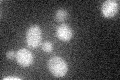
YDR259C
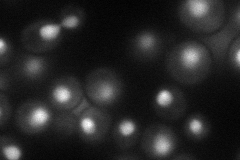
YDR259C
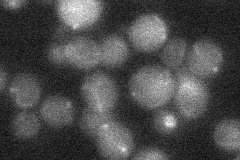
YDR259C
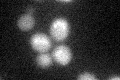
YDR259C
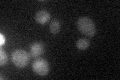
YDR259C

View description
Putative basic leucine zipper (bZIP) transcription factor; overexpression increases sodium and lithium tolerance; computational analysis suggests a role in regulation of expression of genes involved in carbohydrate metabolism
Localization:
Intensity:
Fold change:
Significance:
-
C’ GFP library in SD
below threshold16.86 -
N' NOP1pr-GFP in SD
nucleus54.6114 -
N' TEF2pr-mCherry in SD

nucleus47.567 -
N' NATIVEpr-GFP in SD
below threshold16.8334 -
N' TEF2pr-VC and Cyto-VN in SD

#N/A0 -
C’ GFP library in SD+DTT
cytosol15.450.91No -
C’ GFP library in SD+H2O2

cytosol18.911.12No -
C’ GFP library in Starvation Media
cytosol28.861.71No -
C’ GFP library on the background of Pup2-DaMP

below threshold -
C’ GFP library on the background of CCT mutant

below threshold17.47581.03572No
